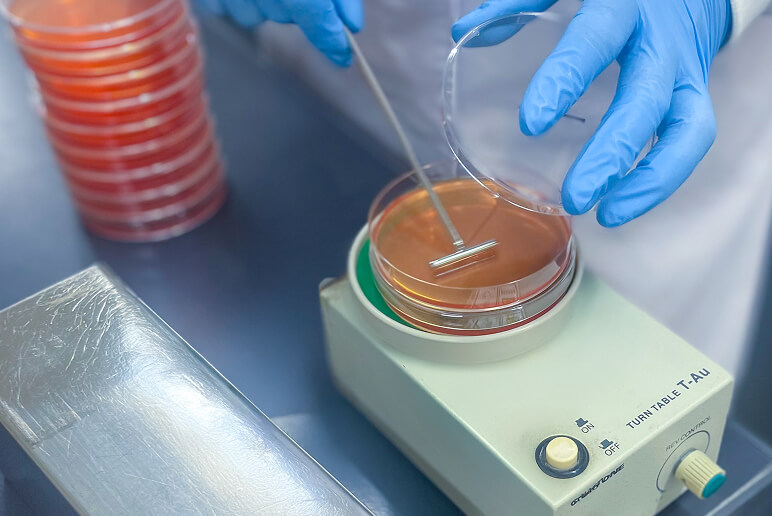

TEIONグループの考え方
TEIONグループは、「食」を提供する企業として、お客様に信頼される安全な製品の提供を最重要理念としています。お客様に安心・安全な製品を届けることを基本に、お客様の立場に立った「必要とされる商品づくり」を日々追求しています。この企業理念に基づき、提供する商品の品質と安全性を確保するため、品質保証に関する基本方針を定めています。

品質保証基本方針
1. お客様の安心と信頼
安心・安全な商品づくりを基本とし、お客様が安心して使える商品をお届けするとともに、社員一人ひとりがお客様の立場に立ち、誠実に商品の品質向上に最善を尽くします。
2. 顧客満足の追求
お客様の声に真摯に耳を傾け、お客様に喜ばれ、長く使い続けていただける高品質な商品を提供し、ご満足いただけるよう努めます。
3. 法令遵守と安定品質
国内外の法令・規則を遵守し、地域・社会・自然との共存を図りながら、常に一定品質の商品をお届けします。
4. 透明な情報提供と信頼構築
お客様に分かりやすい情報を提供し、全ての社員がお客様の声に心から耳を傾け、信頼される企業活動と品質向上に努め、お客様の信頼に応えます。
具体的な取り組み
ISO22000の認証取得
2024年、TEIONグループの株式会社エス・ティ・フーズは、食品安全マネジメントシステムの国際標準規格である「ISO22000」を認証取得しました。ISO22000は、HACCPの食品衛生管理手法を基礎とし、食品安全リスクを低減し、安全なフードサプライチェーンの展開を実現するために制定された国際規格です。

日本冷凍食品協会認定工場
TEIONグループの株式会社エス・ティ・フーズは、冷凍食品の品質と安全への取り組みが評価され、一般社団法人日本冷凍食品協会による「冷凍食品認定制度」の認定工場となっています。この認定制度は、消費者が安心して冷凍食品を選べるよう、工場の衛生管理や品質管理のレベルを第三者の視点から厳格に評価するものです。

HACCPに沿った衛生管理
TEIONグループの生産工場では、HACCP(危害分析重要管理点)に沿った衛生管理を徹底しています。HACCPは、食中毒菌汚染や異物混入などの危害要因(ハザード)を原材料の入荷から製品出荷までの全工程で把握し、それらを除去または低減するために特に重要な工程を管理することで、製品の安全性を確保する衛生管理手法です。

品質保証部による検査
TEIONグループの生産工場では、品質検査室にて原材料の鮮度や残留農薬の検査、完成商品の微生物・官能検査などを実施しています。加えて、自社検査だけでなく、第三者機関にも品質分析検査を依頼し、外部の厳しい目による評価も取り入れています。